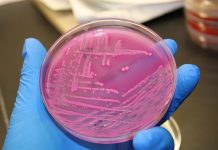
Hygiëne vakantieparken in Nederland onder de maat

Op 1 mei 2017 zal de eerste paal de grond in gaan van een nieuw project van Roompot Projects. Het betreft een nieuw vakantieresort in het Zeeuwse Nieuwvliet-Bad. Roompot Projects is de nieuwe projectontwikkelingstak van vakantieparken-keten Roompot Vakanties. Het vakantieresort bij Nieuwvliet-Bad is het eerste project wat uit deze tak voortkomt. Met de bouw van het nieuwe vakantiepark is een investering van 125 miljoen euro gemoeid.
Noordzee Beach Village
Het vakantieresort aan zee met de naam ‘Noordzee Beach Village’ zal naar verwachting plaats bieden aan 2500 tot 3000 gasten bij een gemiddelde bezetting. Deze gasten worden verdeeld over 562 accommodaties, waaronder 202 lodges, 40 beachhouses en 320 vakantiewoningen. De accommodaties zullen plaats bieden aan 4 tot 16 personen. Meer dan de helft van de accommodaties is inmiddels verkocht, waarvan 20 procent aan Belgen. De realisatie wordt zoveel mogelijk tot stand gebracht met lokale partijen, zodat de investering de lokale economie ten goede komt. Ook zal het vakantieresort naar verwachting op termijn 300 (indirecte) banen opleveren.
Jurgen van Cutsem: “we optimaliseren de biodiversiteit op ons resort”
Roompot is het eerste Nederlandse recreatiebedrijf dat zich heeft aangesloten bij het Belgisch-Nederlandse project 2B Connect, dat streeft naar meer biodiversiteit op bedrijventerreinen in de grensstreek tussen Nederland en België. Samen met de Zeeuwse Milieufederatie en Landschapsbeheer Zeeland wordt er bij het nieuwe vakantieresort extra aandacht besteed aan het creëren van een harmonieuze situatie tussen de gasten en flora en fauna. Jurgen van Cutsem, CEO van Roompot Vakanties, stelt dat het verduurzamen van de vakantieparken past bij het EU-beleid om de relatie tussen economie en ecologie te verbeteren.